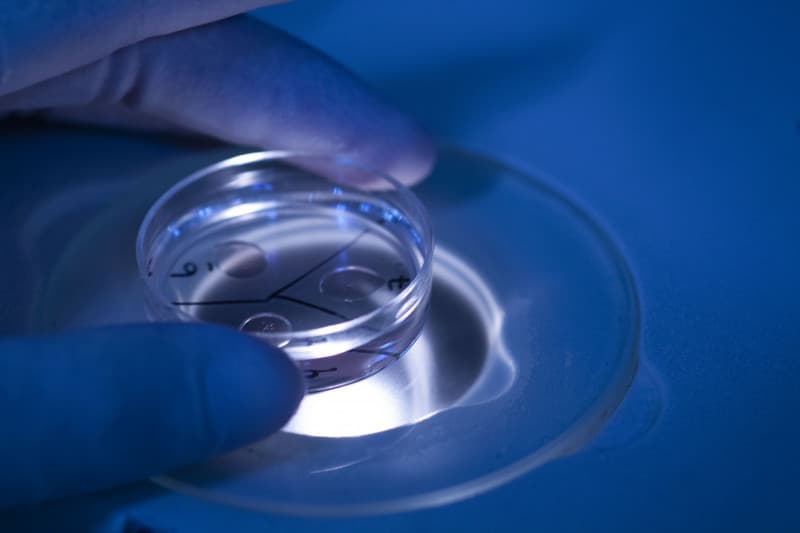
Produção e comercialização de meios para laboratórios
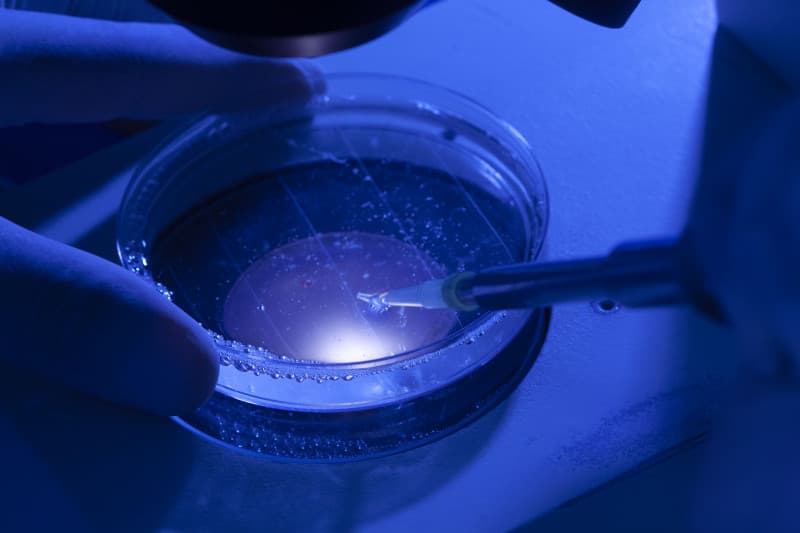
Transferência de embriões
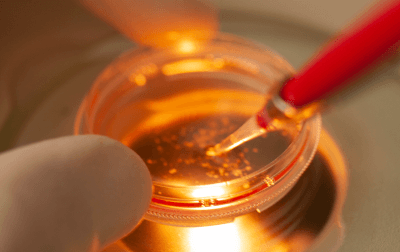
Produção in vitro de embriões bovinos

A Embryo em números
Somos especialistas em:
Produção e comercialização de meios para laboratórios
A Embryo, que é detentora de tecnologia própria, é referência em produção de meios de produção in vitro de embriões, contando com profissionais altamente qualificados para atuarem em todos os processos.
Produção in vitro de embriões (PIV)
É uma metodologia artificial para produção de embriões, que garante melhoramento genético animal e aumento da produtividade.
- Maturação in vitro (MIV)
Os oócitos selecionados são cultivados por 24 horas no laboratório (período que passam pelo processo de maturação e se tornarão aptos para a fecundação e o desenvolvimento embrionário).
- Fecundação in vitro (FIV)
Os oócitos maturados são fecundados com espermatozoides de sêmen congelado, de livre escolha do criador. Dependendo da concentração e qualidade do sêmen, uma única dose pode ser utilizada para fecundar de 50 a 400 oócitos.
- Cultivo in vitro (CIV)
Os oócitos fecundados ficam incubados in vitro por 6 dias. Os embriões que se desenvolverem e forem classificados como aptos serão transferidos para o útero de receptoras ou submetidos ao processo de criopreservação.
Congelação de Embriões (DT – Vitrificação)
Congelação de embriões ou criopreservação são técnicas utilizadas para a preservação e estocagem de embriões.
- Direct Transfer (DT)
Técnica de congelamento lento com utilização de equipamento específico. Os embriões congelados para Transferência Direta podem ser descongelados diretamente na fazenda, de forma simples, como uma dose de sêmen para inseminação artificial tradicional e imediatamente transferidos para a receptora.
- Vitrificação (VIT)
Técnica de congelamento ultrarrápida, onde os embriões são expostos diretamente ao nitrogênio líquido. Os embriões de FIV excedentes ou pré-programados podem ser submetidos ao processo para estocagem ou comercialização de sua genética, e requerem um processo de descongelamento complexo, que pode ser realizado apenas pelo laboratório ou veterinários bem treinados.
Assessoria Embryo
Acompanhamento individual das doadoras, com avaliação reprodutiva, controle de onda folicular, tratamento de animais com problemas reprodutivos e total assistência reprodutiva no rebanho.
Aspiração folicular
As aspirações foliculares são realizadas por uma equipe de campo especializada, acompanhadas de um exame de ultrassonografia diretamente dos ovários das fêmeas bovinas. Todo o material é identificado e selecionado para o processo de produção in vitro dos embriões. O transporte é feito por meio de estufas, com total segurança e meio adequado, podendo suportar até 22 horas de viagem até o laboratório.
Transferência de embriões
- As receptoras são avaliadas quanto ao seu estado reprodutivo e, apenas aquelas consideradas aptas, recebem os embriões que foram produzidos via PIV. O procedimento é feito por um médico veterinário capacitado, por meio de método não cirúrgico, sendo o embrião depositado na luz do corno uterino.

.jpg&w=3840&q=75)




Venda de Embriões
Genética: o único insumo da agropecuária que é cumulativo e permanente!
.jpg&w=3840&q=75)
Quer aumentar a rentabilidade da sua fazenda e melhorar a reprodução do seu rebanho?
Entre em contatoQualidade, Credibilidade e Tecnologia de ponta!
Com quase 20 anos de atuação, a Embryo é referência no uso de biotecnologia de reprodução animal, utilizando técnicas de produção in vitro e criopreservação de embriões. Contando com profissionais qualificados e detentora de tecnologia própria, é a parceira ideal para o melhoramento genético, seleção e desenvolvimento das raças bovinas, fatia do mercado de maior importância e relevância do agronegócio nacional.
Total aprovação dos nossos clientes e parceiros
Parceiros

Precisa acelerar o melhoramento genético de rebanhos leiteiros e gado de corte?
Fale com um especialista!Por que escolher a Embryo?
Conheça nosso laboratório




Curso de qualificação profissional

Lorem Ipsum

Produção in vitro de embriões bovinos

Congelação de embriões (Direct Transfer e Vitrificação)

Lorem Ipsum





_(1).png&w=3840&q=75)








.png&w=3840&q=75)